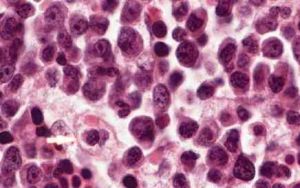
噬血細胞綜合徵——淋巴增生

簡介
 噬血細胞綜合徵
噬血細胞綜合徵噬血細胞綜合徵(hemophagocyticsyndrome,HPS),是一組骨髓、脾臟、淋巴結等造血組織中良性、反應性增生的組織細胞吞噬自身血細胞而引發的一系列臨床病症。臨床表現為持續高熱,肝、脾、淋巴結大,外周血細胞減少,肝功能異常,凝血功能障礙等。1979年首先由Risdull等報告,多發於兒童。可由感染病毒,或是因為用藥不當,以及體內有腫瘤(對於小孩來說腫瘤幾率低)等誘發,由於嬰幼兒自身抵抗能力弱,調節不當,致使單核巨噬細胞增生而且對自身血細胞發生攻擊並消除,使得嬰兒貧血導致死亡。
分類
原發性
原發性HPS,或稱家族性HPS,為常染色體隱性遺傳 病,其發病和病情加劇常與感染有關。繼發性
繼發性HPS分為感染相關性HPS(infection-associatedhemophagocyticsyndrome,IAHS),此型多與病毒感染有關,由病毒引起者稱病毒相關性HPS(virus-associatedhemophagocyticsyndrome,VAHS);由腫瘤引起者稱腫瘤相關性HPS(malignancy-associatedhemophagnocyticsyndrome,MAHS)。
流行病學
本病以兒童多見,男性多於女性。兒童原發性HLH(FHL)的年發病率約為0.12/1O萬,80%的患者在2歲以前發病。繼發性HPS在任何年齡均可發病。所以,一般認為2歲前發病者提示的原發性可能性大,8歲後發病者則提示繼發性的可能性大,2-8歲發病者則根據臨床表現進行判斷。在日本和亞洲國家發病率較高。本病來勢兇險,東方患者的死亡率約為45%。
病因
 巨噬細胞
巨噬細胞HPS可以看作細胞因子病(cytokine disease),或巨噬細胞激活綜合徵。作為免疫應答的反應性T細胞(Th1和Tc)和單核吞噬細胞過度分泌淋巴、單核因子〔巨噬細胞增生的誘導因子(PIF)〕激活巨噬細胞。惡性細胞亦可直接刺激組織細胞,或由腫瘤細胞產生釋放細胞因子(如γ-干擾素),誘發臨床綜合徵,稱之為副新生物綜合徵(para-neoplastic syndrome)。高細胞因子血症作為血細胞減少和器官衰竭的中間機制。CD+4T細胞分泌誘導巨噬細胞增生的因子(PIF)為HPS的始動因素。IFNγ和TNF-α引起骨髓造血抑制,IFN-γ、TNFα和IL-1導致發熱、肝功能異常、高脂血症及凝血障礙。可溶性白介素2受體(sIL-2R)的過度增高結合IL-2可作為抑制正常免疫反應的“阻斷因子”導致繼發性免疫缺陷狀態。21世紀初公認的HPS患者血細胞減少有多種因素參與:
1、噬血細胞增多,加速血細胞的破壞;
2、血清中存在造血祖細胞增殖的抑制性物質,骨髓內粒系和紅系前體細胞和巨核細胞進行性減少,歸因於抑制性單核因子和淋巴因子的產生,諸如γ-干擾素、腫瘤壞死因子(TNF)和白介素-1以及造血生長抑制因子的產生。
發病機制
1、存在免疫調節障礙或免疫失衡。
2、淋巴和單核因子持續產生,作為免疫應答的反應性T細胞分泌淋巴因子可活化巨噬細胞,尤其如γ-干擾素不僅能抑制造血,而且亦能活化巨噬細胞,淋巴因子GM-CSF亦激活巨噬細胞。
3、遺傳因素影響機體對感染的反應方式,如家族性噬紅細胞性淋巴組織細胞增生症和X聯淋巴增殖綜合徵的兒童可發生類似的血液學異常。
4、存在單克隆性T細胞增殖,在EB病毒相關噬血細胞綜合徵(EBV-AHS)的患者採用PCR法檢測10/11例呈TCRγ鏈重排,亦有報導TCRβ基因的單克隆性重排,顯示EB病毒感染T細胞引起單克隆增殖的可能,或許是末梢T細胞“腫瘤”的一種特殊類型。EBV-AHS患者EBV整合入宿主T細胞染色體基因組造成單克隆T細胞增生(從良性到新生物前期或明顯的惡性增殖)伴異常的T細胞。為何異常的T細胞反應導致組織巨噬細胞的吞噬行為改變,可能由T細胞過度分泌的淋巴因子所介導。
病理特徵
良性組織細胞增加並伴嗜血現象,多見於淋巴結的淋巴竇和髓索、肝竇、門靜脈、脾臟的紅髓和骨髓。在急性期,該病與白血病、惡性組織細胞增生症、傳染性單核細胞增生症等病相似,且並非所有病例第一次骨穿即能發現嗜血細胞,有時需多部位穿刺才能確診。
骨髓多增生活躍,粒系統所占比例降低,中性粒細胞可見毒性變。幼紅系統增生多正常,淋巴系統比例亦未見明顯改變,可見異型淋巴細胞。單核巨噬系統增生活躍,常>10%,巨噬細胞大小為20~40微米,或更大,胞漿豐富,吞噬多個成熟紅細胞,或幼紅細胞或血小板等。巨核細胞大致正常。
臨床表現
家族性噬血細胞綜合徵
 噬血細胞綜合徵——皮疹
噬血細胞綜合徵——皮疹發病年齡一般早期發病,70%發生於1歲以內,甚至可在生前發病,出生時即有臨床表現。多數在嬰幼兒期發病,但也有遲至8歲發病者。成年發病亦不能排除家族性HPS。
在同一家族中,其發病年齡相似。症狀體徵,症狀多樣,早期多為發熱、肝、脾腫大,有的有皮疹、淋巴結腫大和神經症狀。發熱持續,亦可自行退熱;肝脾腫大明顯,且呈進行性;皮疹無特徵性,常為一過性,往往出皮疹時伴高熱;約有一半病人有淋巴結腫大,有的有巨大淋巴結。中樞神經系統的症狀一般在病程晚期出現,但也可發生在早期,表現為興奮性增高、前囟飽脹、頸強直、肌張力增強或降低、抽搐等。亦可有第VI或第VII對顱神經麻痹、共濟失調偏癱或全癱、失明、意識障礙、顱內壓增高等。肺部的症狀多為肺部淋巴細胞及巨噬細胞浸潤所致,但難與感染鑑別。
繼發性噬血細胞綜合徵
1、感染相關性噬血細胞綜合徵(IAHS)
嚴重感染引起的強烈免疫反應,淋巴組織細胞增生伴吞噬血細胞現象,本病常發生於免疫缺陷者,由病毒感染所致者稱病毒相關性HPS(VAH),但其它微生物感染,如細菌、真菌、立克次體、原蟲等感染也可引起HPS。其臨床表現除有HPS的共同表現(如前所述)外,還有感染的證據。骨髓檢查有淋巴組織細胞增生,並有吞噬紅細胞、血小板和有核細胞現象。
2、腫瘤相關性噬血細胞綜合徵
本病分為兩大類:一類是急性淋巴細胞白血病(急淋)相關的HPS,急淋在治療前或治療中可能合併有感染或沒有感染伴發的HPS。除急淋外,縱隔的精原細胞瘤(mediactinalgermcelltumor)也常發生繼發性HPS。
第二類是淋巴瘤相關的HPS(lymphoma-associatedhemophagocytic,syndrome,LAllS),淋巴瘤常為亞臨床型,沒有淋巴瘤的表現,故往往誤診為感染相關性HPS,特別容易誤診為EB病毒相關性淋巴瘤。
併發症
出血、感染、多臟器功能衰竭和DIC。
輔助檢查
血象
多為全血細胞減少,以血小板減少為明顯,白細胞減少的程度較輕;觀察血小板的變化,可作為本病活動性的一個指征。病情緩解時,首先可見到血小板上升;而在病情惡化時,亦首先見到血小板下降。
骨髓象
噬血細胞綜合徵——淋巴增生
噬血細胞綜合徵——淋巴增生骨髓在疾病早期的表現為中等度的增生性骨髓象,噬血現象不明顯,常表現為反應性組織細胞增生,無惡性細胞浸潤,應連續多次檢查骨髓,以便發現吞噬現象。該病的極期除組織細胞增多外,有多少不等的吞噬性組織細胞,主要吞噬紅細胞,也可吞噬血小板及有核細胞。
骨髓增生度降低,這很難與細胞毒性藥物所致的骨髓抑制鑑別。有的病例其骨髓可見大的顆粒狀淋巴細胞,胞體延長如馬尾或松粒狀,這可能是HPS的一種特殊類型的淋巴細胞。
高細胞因子血症
在家族性HPS及繼發性HPS的活動期常見下列因子增多:IL-l受體拮抗因子、可溶性IL-2受體(sIL-2)、γ-干擾素(IFN-γ)、腫瘤壞死因子(TNF)等。
血脂
可見甘油三酯增多,可在疾病的早期出現,脂蛋白電泳常見極低密度脂蛋白膽固醇及低密度脂蛋白膽固醇升高,高密度脂蛋白膽固醇降低。當病情緩解時,脂蛋白膽固醇可恢復正常。
肝功能
轉氨酶及膽紅素可增高,其改變的程度與肝受累的程度一致。在全身感染時,可有低鈉血症、低白蛋白血症及血清鐵蛋白增多。
凝血象
在疾病活動時,常有凝血異常,特別是在疾病活動期,有低纖維蛋白原血症,部分凝血活酶時間延長,在有肝受損時,其凝血酶原時間可延長。
腦脊液
中等量的細胞增多(5-50×106/L),主要為淋巴細胞,可能有單核細胞,但很少有噬血細胞,蛋白增多,但有的即使有腦炎的臨床表現,其腦脊液亦可能正常。
免疫學檢查
家族性HPS常有自然殺傷細胞及T細胞活性降低。
影像檢查
部分病人胸片可見間質性肺浸潤,晚期病人頭顱CT或MRI檢查可發現異常,其改變為陳舊性或活動性感染,脫髓鞘,出血,萎縮或(及)水腫。有時亦可通過CT檢查發現腦部鈣化。
診斷
診斷標準
1、發熱超過1周,高峰≥38.5℃;
2、肝脾腫大伴全血細胞減少(累及≥2個細胞系,骨髓無增生減低或增生異常);
3、肝功能異常(血LDH≥正常均值+3SD,一般≥1000U/L)及凝血功能障礙(血纖維蛋白原≤1.5g/L),伴高鐵蛋白血症(≥正常均值+3SD,一般≥1000ng/ml);
4、噬血組織細胞占骨髓塗片有核細胞≥3%,或和累及骨髓、淋巴結、肝、脾及中樞神經系統的組織學表現。
鑑別診斷
鑑別診斷最容易混淆的是家族性HPS與繼發性HPS,特別是與病毒相關性HPS的鑑別,因為病毒感染不但與病毒相關性HPS有關,在家族性HPS患者,也常有病毒感染,而且家族性HPS也常由病毒感染而誘發。家族性HPS為常染色體隱性遺傳病,常問不到家族史,更增加了診斷的難度。
一般認為,在2歲前發病者多提示為家族性HPS,而8歲後發病者,則多考慮為繼發性HPS。在2~8歲之間發病者,則要根據臨床表現來判斷,如果還難肯定,則應按家族性HPS處理。其次要與惡性組織細胞病(惡組)相鑑別,二者在骨髓片上很難鑑別,但HPS要比惡組常見得多。但如臨床上呈暴發經過、嚴重肝功能損害、骨髓中組織細胞惡性程度高,特別是肝、脾或其他器官發現異常組織細胞浸潤,則先考慮為惡組為宜;否則應診斷為HPS。
治療
原發性HPS或病因不明未檢出明顯潛在疾患者除加強支持治療和併發症的治療外,目前(21世紀初)尚無特效治療,根本性治療是同種異體造血幹細胞移植。繼發性HPS應作病因探索,治療應以基礎病與HPS並重。
家族性噬血細胞綜合徵
 噬血細胞綜合徵治療
噬血細胞綜合徵治療1、化學療法:常用的化療藥物有細胞毒性藥物,如長青花鹼或長春新鹼與腎上腺皮質激素聯用,亦可套用反覆的血漿置換,或VP16或VM26與腎上腺皮質激素合用。有的套用VP16、腎上腺皮質激素,鞘內注射氨甲煤呤(MTX)及頭顱照射治療取得良好效果。有的主張在緩解時,套用上述藥物小劑量維持治療。
2、免疫治療:有人用環胞菌素A治療家族性HPS取得滿意效果,同樣,用抗胸腺細胞球蛋白(ATG)亦可誘導緩解。
3、造血幹細胞移植:儘管上述化療可使病情緩解,有的可緩解9年,但仍不能根治家族性HPS。Fisher等(1986)首先報告用骨髓移植治癒家族性HSP患者,在2000年上海舉行的國際小兒血液腫瘤學術研討會上,日本學者Imashukn報告5例由EBV所致的HPS,套用造血幹細胞移植,隨後用環胞菌素A加VP16,大大改善了本病的預後。
4、治療方案:國際組織細胞協會1994年提出一個治療家族性HPS的方案(HLH94):地塞米松每日10mg/m2與VP16每周150mg/m2,連用3周,第4周起減量,第9周起VP16每2周用藥1次,並加用環胞菌素A每日5~6mg/kg口服,共用1年。有神經症狀者,前8周每2周鞘內注射MTX1次。如果是家族性HPS,爭取做異基因造血幹細胞移植。如果為非家族性HPS,則在8周治療後根據病情停止治療。
繼發性噬血細胞綜合徵
繼發性HPS針對病因進行相應治療。
1、對HPS或高細胞因子血症的治療對策為:
(2)、靜脈滴注大劑量丙種球蛋白(多用於VAHS);
(3)、抑制T細胞活化的特異性抑制劑環孢菌素A或聯用G-CSF治療VAHS,或抗胸腺細胞球蛋白;
(4)、直接拮抗細胞因子的抗TNF抗體和IL-1受體拮抗劑;
(5)、為抑制或減少淋巴因子的供應源可採用化療。包括CHOP、CHOPE方案或緩慢靜滴長春新鹼。屢已報導套用依託泊甙(VP16)治療原因不明的重症HPS、EBV-AHS或LAHS奏效。預後分析表明,對於不易與MH鑑別的HPS患者啟用化療是必需的;
(6)、骨髓掃蕩性(根治性)治療和異基因骨髓移植(allo-BMT)或外周血幹細胞移植治療FHL或耐化療的LAHS或EBV-AHS病例,優於常規化療和免疫抑制治療。
2、腫瘤相關性噬血細胞綜合徵治療方案決定於疾病的類型,如HPS發生於治療前的免疫缺陷患者,則治療主要是抗感染及抗腫瘤;如果HPS發生於化療後,而腫瘤已緩解則應停止抗腫瘤治療,同時抗感染,加用腎上腺皮質激素及VP16;對進展迅速的MAHS則應針對細胞因子所致的損害進行治療,可用前述HLH94方案。
預後
HPS預後不良,原發性HPS確診後如不治療,均在短期內死亡,存活>1年者不到10%,繼發性HPS從輕微病例到致死病例均可發生,其中感染相關HPS病死率為20%-42%,腫瘤相關HPS病死率幾乎為100%。
預後取決於潛在疾患的嚴重性及細胞因子暴(cytokinestorm)的強度,約有半數病例死亡。呈暴發性經過者病情急劇惡化,4周內死亡。生存者1~2周血細胞數恢復,肝功能恢復需較長時間(3~4周)。血液惡性疾患患者中,合併HPS和不合併HPS組平均生存期分別為7個月、48個月,呈顯著性差異。T/NK-LAHS患者預後絕對不良。主要死亡原因為出血、感染、多臟器功能衰竭和DIC。
病例
2013年5月,廣元市的8歲女孩程思怡被診斷患有嗜血細胞綜合症,因大量服用激素藥物,程思怡的體重與日俱增。11月4日,程思怡在華西醫院接受化療,醫生讓其住院治療,因缺錢只得回家等待下一次化療。而長時間的化療僅僅能控制程思怡體內的嗜血細胞的數量增長速度,且她血液內的EBV病毒含量已經超高,隨時都可能會奪走這顆幼小的生命。


